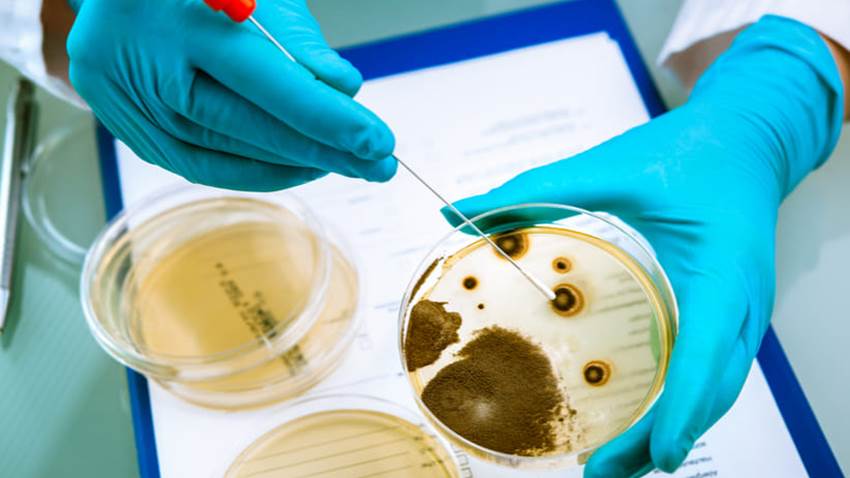
Ser alérgico a los antibióticos e ingerirlos crearía ‘resistencia antibiótica’

Dr. Colón:“Prefiero la vacuna de Pfizer y Moderna para el paciente envejeciente o con condiciones de morbilidad”
Marcela Moreno WilchesAgencia Latina de Noticias Medicina y Salud Pública En entrevista exclusiva con la revista Medicina y Salud Pública (MSP), el Dr...